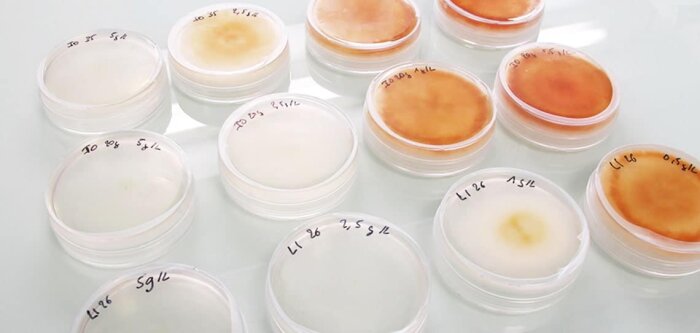

Bientôt une microalgue antifongique en traitement de semences
La startup ImmunRise Biocontrol annonce avoir levé 5 M€ pour finaliser le développement d’une microalgue antifongique. L’entreprise ambitionne de mettre sa solution sur le marché dès 2026, en traitement de semences grandes cultures et potagères et en application foliaire contre le mildiou de la vigne. Elle compte désormais à son capital, aux côtés du groupe Baron Philippe de Rothschild (BPhR), la société De Sangosse.
Spin off de l’Ecole normale supérieure, la startup girondine ImmunRise Biocontrol, annonce, le 4 juillet 2022, avoir levé 5 M€ et avoir désormais à son capital, aux côtés du groupe Baron Philippe de Rothschild (BPhR), investi dans la viticulture française, la société De Sangosse. L’entreprise, créée en 2015 par Lionel Navarro, directeur de recherche au CNRS et Laurent de Crasto, ingénieur agronome et oenologue, va ainsi pouvoir accélérer les dernières phases de développement de sa microalgue antifongique « Amphidinium carterae » et apporter ainsi à l’agriculture une solution biopesticide sur un large spectre de maladies.
Mise en marché dès 2026
Depuis trois ans, ImmunRise Biocontrol a conduit une centaine de traitements sur de nombreuses cultures avec, entre autres, l’expertise d’Arvalis. Des programmes d’essais de lutte contre le mildiou de la vigne ont permis de constater une efficacité de 95 %. D’autres ont été menés sur des semences grandes cultures et potagères. La startup prévoit une mise sur le marché dès 2026 sur ces segments. Un déploiement de l’activité est d’ores et déjà programmé à l’échelle européenne puis, à moyen terme, sur les marchés américains du Nord et du Sud. Des partenariats ont déjà été établis en France et à l’étranger.
« ImmunRise Biocontrol développe des solutions de biocontrôle à partir d’actifs marins issus de sa propre recherche qui démontrent une efficacité sur un spectre unique de pathosystèmes », souligne Nicolas Fillon, directeur général de De Sangosse, justifiant ainsi son soutien au développement de la startup et à la mise sur le marché de cette microalgue antifongique.